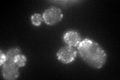
YLR370C
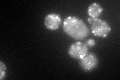
YLR370C

View description
Subunit of the ARP2/3 complex, which is required for the motility and integrity of cortical actin patches
Localization:
Intensity:
Fold change:
Significance:
-
C’ GFP library in SD

punctate127.28 -
N' NOP1pr-GFP in SD

punctate,bud186.489 -
N' TEF2pr-mCherry in SD

punctate,bud neck70.814 -
N' NATIVEpr-GFP in SD

below threshold85.4375 -
N' TEF2pr-VC and Cyto-VN in SD

#N/A0 -
C’ GFP library in SD+DTT
punctate125.710.98No -
C’ GFP library in SD+H2O2
punctate91.370.71No -
C’ GFP library in Starvation Media

punctate163.971.28No -
C’ GFP library on the background of Pup2-DaMP

punctate -
C’ GFP library on the background of CCT mutant

punctateN/AN/ANo
